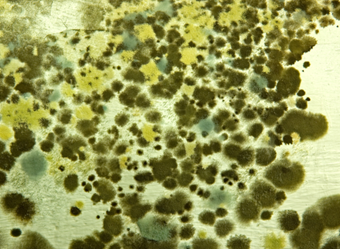
Mold spores floating through the air

5 Things That Could Be Lurking in Your Air Ducts Right NOW!
Have you been dealing with constant sneezing or itchy eyes? You might need your ducts cleaned. Your ducts do more than just move air; they can also collect unwanted things that impact your home’s air quality and your health. Here are five things that might be hiding in your ducts right now:
- Dust and debris: Over time, dust, dirt, and debris accumulate in your ductwork. This buildup can circulate throughout your home, aggravating allergies and respiratory issues.

- Mold and mildew: Moisture in your HVAC system creates the perfect environment for mold and mildew to grow. These can spread spores through your air, causing health problems like headaches, fatigue, and sinus issues.
- Pet dander: Even if you clean regularly, pet dander can find its way into your ducts, sticking around long after it’s shed. This can trigger allergies and reduce air quality.

- Pests and insects: Insects, rodents, and other pests can make their way into ductwork, leaving behind droppings, nesting materials, and even remains — all of which can contaminate the air you breathe.

- Bacteria and viruses: Your ducts can circulate airborne bacteria and viruses throughout your home, contributing to illness, especially during cold and flu season.

Keeping your ducts clean is about protecting your family’s health and safety. Dust, allergens, and other hidden contaminants can impact the air you breathe every day. If you’re worried about what might be lurking in your ducts, don’t wait. Call us now.
Our team at JD Service Now is ready to take great care of you and your home with professional duct cleaning services that keep your air fresh, clean, and safe.
Contact us today for expert duct cleaning.
Recent Posts
Finance Now & Get Approved Today!
Don’t Sacrifice Your
Family’s Comfort!
FIND Out MORE
Family’s Comfort!
Recent Posts
Request Service
Get the fast, affordable HVAC, plumbing, or electrical services you deserve by filling
out the form below.
Request Service
Sign up for the Always Right
Home Partnership Program
Our 100% Worry-Free Home Service Plans
Experience unmatched peace of mind when you invest in our Home Partnership Program. From priority service, seven days a week, to 10% off all service and repairs, when you become a member of our home service plan, you can rest assured that our reliable team will keep your home’s comfort systems operating smoothly. Learn more about the HVAC, plumbing, and electrical benefits you’ll get when you sign up!
LEARN MORE